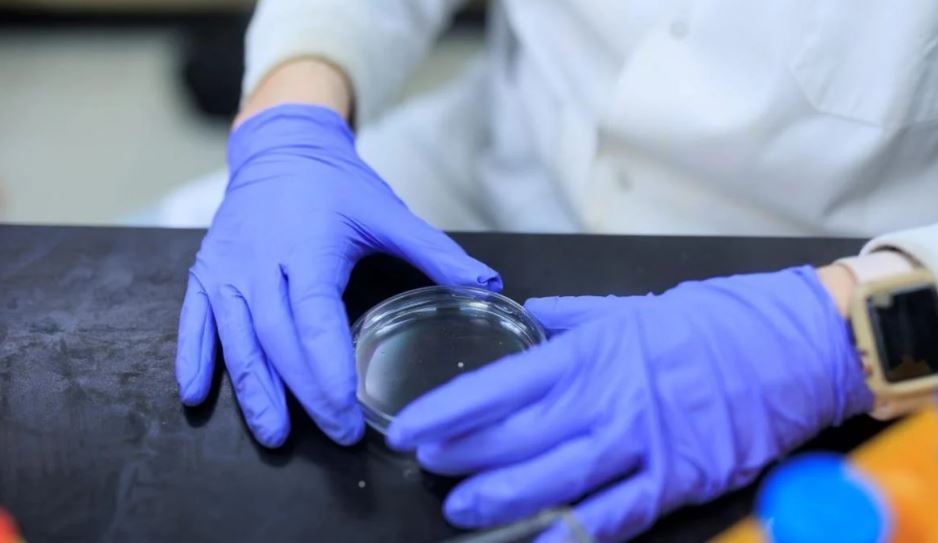

"مینی مغز" ساخته شده از خون، انقلابی در درمان آلزایمر/ ایدهای که دیوانگی را به علم تبدیل کرد!

به گزارش خبرنگار گروه علم و فناوری خبرگزاری برنا؛ تایلر ونزل در دانشگاه ساسکاچوان "مینیمغز" را از سلولهای بنیادی انسان توسعه داده است، با هدف ایجاد انقلاب در تشخیص و درمان آلزایمر. این پیشرفت میتواند بهطور قابلتوجهی به مناطق دورافتاده کمک کند، بار سیستم مراقبتهای بهداشتی را کاهش دهد و به سایر شرایط مرتبط با مغز گسترش یابد.
"مینیمغز" که توسط ونزل با استفاده از سلولهای بنیادی توسعه یافته، میتواند درمان و تشخیص آلزایمر را تغییر دهد و نشاندهنده پتانسیل کاربردهای پزشکی گستردهتر و ارائه مراقبتهای بهداشتی کارآمدتر است.
تایلر ونزل از دانشگاه ساسکاچوان (USask) یک روش نوآورانه جدید برای ساخت مغز مینیاتوری از سلولهای بنیادی طراحی کرده است. "مینیمغز" ونزل میتواند در تشخیص و درمان آلزایمر و سایر بیماریهای مرتبط با مغز انقلابی ایجاد کند.
او اظهار داشت: هیچوقت در دیوانهترین رویاهایمان فکر نمیکردیم که ایده دیوانهوار ما جواب دهد. این میتواند بهعنوان یک ابزار تشخیصی ساخته شده از خون استفاده شود.
ونزل، یک عضو پسادکترا در بخش روانپزشکی کالج پزشکی، ایده "مینیمغز" - یا بهطور رسمیتر، یک مدل ارگانوئید مغزی منحصر به فرد - را در حین کار تحت نظارت دارل موسو (PhD) توسعه داد.

قابلیتهای منحصر به فرد ارگانوئیدهای مشتق از سلولهای بنیادی
سلولهای بنیادی انسان میتوانند بهگونهای دستکاری شوند که بهطور عملی به هر سلول دیگری در بدن تبدیل شوند. با استفاده از سلولهای بنیادی گرفته شده از خون انسان، ونزل توانست یک عضو مصنوعی کوچک ایجاد کند که تقریباً سه میلیمتر عرض دارد و شبیه به آنچه که ونزل بهعنوان یک قطعه آدامس جویدهشده توصیف کرد، است.
این "مغزهای کوچک" با ایجاد سلولهای بنیادی از نمونه خون و سپس تبدیل این سلولهای بنیادی به سلولهای مغزی کارآمد ساخته میشوند. استفاده از ارگانوئیدهای مصنوعی کوچک برای تحقیق یک مفهوم جدید نیست، اما "مینیمغز" توسعهیافته در آزمایشگاه ونزل منحصر به فرد است. همانطور که در مقاله اخیر ونزل در Frontiers of Cellular Neuroscience شرح داده شده است، مغز آزمایشگاه ونزل از چهار نوع مختلف سلول مغزی تشکیل شده است، درحالیکه بیشتر ارگانوئیدهای مغزی فقط از نورونها تشکیل شدهاند.
در آزمایشها، "مینیمغز" ونزل با دقت بیشتری مغز انسان بالغ را منعکس میکند، بنابراین میتوان از آن برای بررسی دقیقتر شرایط عصبی بیماران بزرگسال مانند بیماری آلزایمر استفاده کرد.

پتانسیل مینیمغز در تشخیص آلزایمر
ونزل مشخص کرد که "مینیمغز" که از سلولهای بنیادی افرادی که آلزایمر دارند، ایجاد شده است، آسیبشناسی آلزایمر را نیز نشان میدهد، فقط در مقیاس کوچکتر.
او گفت: اگر سلولهای بنیادی توانایی تبدیل شدن به هر سلول در بدن انسان را داشته باشند، این سؤال مطرح میشود که آیا میتوانیم چیزی شبیه به یک عضو کامل ایجاد کنیم؟
او افزود: درحالیکه ما در حال توسعه آن بودیم، این ایده دیوانهوار را داشتم که اگر این واقعاً مغز انسان باشد و اگر یک بیمار بیماری مانند آلزایمر داشته باشد و ما 'مینیمغز' او را رشد دهیم، در تئوری، این مغز کوچک آلزایمر خواهد داشت.
این محقق گفت که این فناوری میتواند شیوه ارائه خدمات بهداشتی به افراد مبتلا به آلزایمر را، بهویژه در جوامع روستایی و دورافتاده، تغییر دهد. این تحقیق پیشگامانه قبلاً از انجمن آلزایمر کانادا حمایت شده است.
گسترش کاربردها و تحقیقات آینده
اگر ونزل و همکارانش بتوانند یک روش ثابت برای تشخیص و درمان بیماریهای عصبی مانند آلزایمر ایجاد کنند، با استفاده از تنها یک نمونه خون کوچک - که عمر نسبتاً طولانی دارد و میتواند ارسال شود - بهجای نیاز به بیماران برای سفر به بیمارستانها یا کلینیکهای تخصصی، میتواند مقدار زیادی از منابع را برای سیستم مراقبتهای بهداشتی ذخیره کند و بار بیماران را کاهش دهد.
او گفت: در تئوری، اگر این ابزار به روشی که ما فکر میکنیم کار کند، ما فقط میتوانیم نمونه خون را از La Loche یا La Ronge به دانشگاه ارسال کنیم و به این شکل شما را تشخیص دهیم.
کار اولیه اثبات مفهوم در "مینیمغز" بسیار امیدوارکننده بوده است، به این معنی که گام بعدی برای ونزل گسترش آزمایش به یک گروه بزرگتر از بیماران است.
محققان همچنین علاقهمند به گسترش دامنه تحقیقات "مینیمغز" هستند. به گفته ونزل، اگر آنها بتوانند تأیید کنند که "مینیمغز" بهطور دقیق سایر بیماریهای مغزی یا شرایط عصبی را منعکس میکند، بهطور بالقوه میتواند برای تسریع در تشخیص یا آزمایش اثربخشی داروها بر روی بیماران استفاده شود.
بهعنوانمثال، ونزل به زمان انتظار قابلتوجهی برای دیدن یک روانپزشک در ساسکاچوان اشاره کرد. اگر از "مینیمغز" برای آزمایش این که کدام داروی ضدافسردگی برای بیمار مبتلا به افسردگی بهتر عمل میکند، استفاده شود، میتواند بهطور چشمگیری زمان لازم برای مراجعه به پزشک و دریافت نسخه را کاهش دهد.
ونزل، معلم سابق علوم دبیرستان که به دنیای تحقیق و دانشگاه وارد شد، گفت که "ماهیت تحقیق" این است که با یک فرضیه به جلو میآیید و در یک آزمایش که او را هیجانزده میکند، به هدف نزدیک میشوید.
بااینحال، موفقیت شگفتانگیز "مینیمغز" اولیه آنقدر حیرتانگیز بوده که ونزل اعتراف کرد که هنوز هم برای فهم کامل آن تلاش میکند.
او گفت: من هنوز باورم نمیشود، اما این نیز بسیار انگیزهبخش است که چیزی شبیه به این اتفاق افتاده است. این به من چیزی میدهد که فکر میکنم بر جامعه تأثیر میگذارد و ارتباط واقعی دارد و تغییراتی ایجاد میکند... این پتانسیل قوی برای تغییر چشمانداز پزشکی دارد.
انتهای پیام/































































